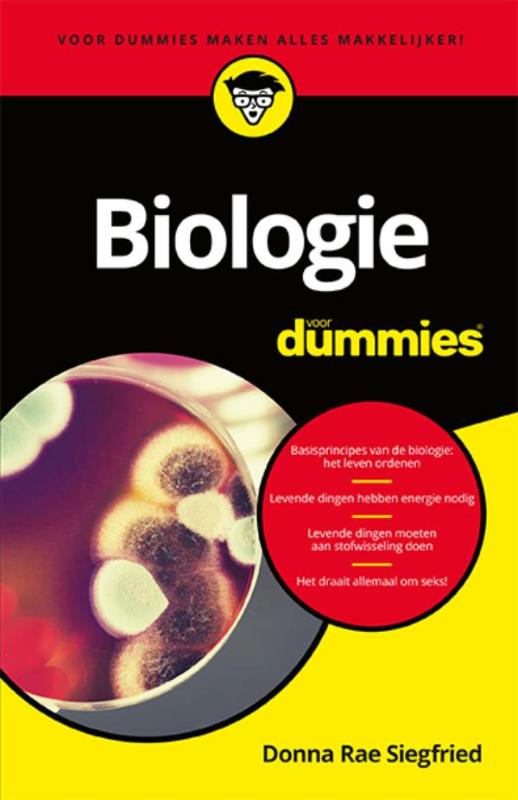
coverImage

Biologie voor Dummies - Donna Rae Siegfried
KORTE INHOUD
Ben je nieuwsgierig naar het mysterie van het leven? Loop dan met een expert mee door de wereld van de biologie: van cellen, stofwisseling en genetica tot de evolutie, ecosystemen en seks. Met de pocketeditie van Biologie voor Dummies zul je ingewikkelde begrippen uit de biologie razendsnel onder de knie krijgen en alles wat leeft beter leren begrijpen.
Donna Rae Siegfried schrijft over farmaceutische en medische onderwerpen in tijdschriften als Runner's World, Men's Health en Organic Gardening. Ook is zij a...
Donna Rae Siegfried schrijft over farmaceutische en medische onderwerpen in tijdschriften als Runner's World, Men's Health en Organic Gardening. Ook is zij a...
Categorie
Details
2016 Uitgever: BBNC Vertaler: SmarterScience 357 paginas Taal: Nederlands Grootte: 216x140x21 ISBN-10: 9045351978 ISBN-13: 9789045351971Helaas, laatste exemplaar van deze editie is recent verkocht!